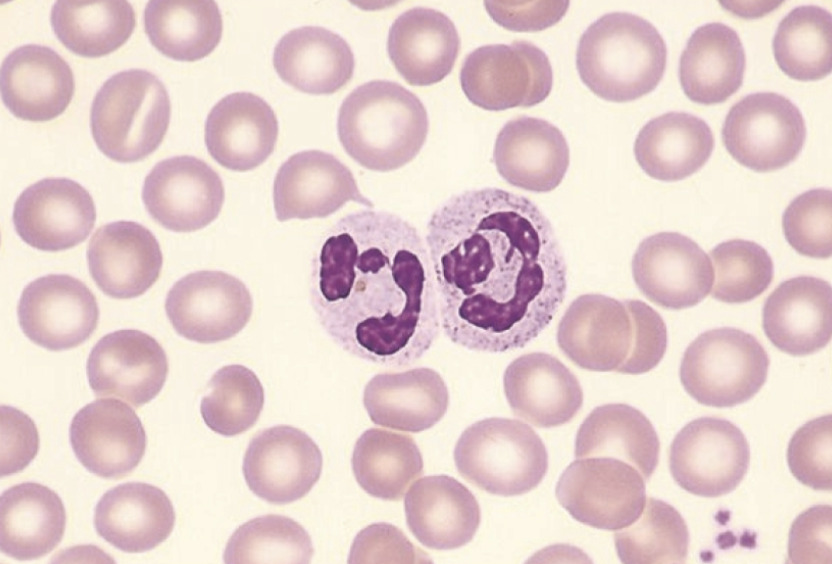
<p>What is this cell?</p>
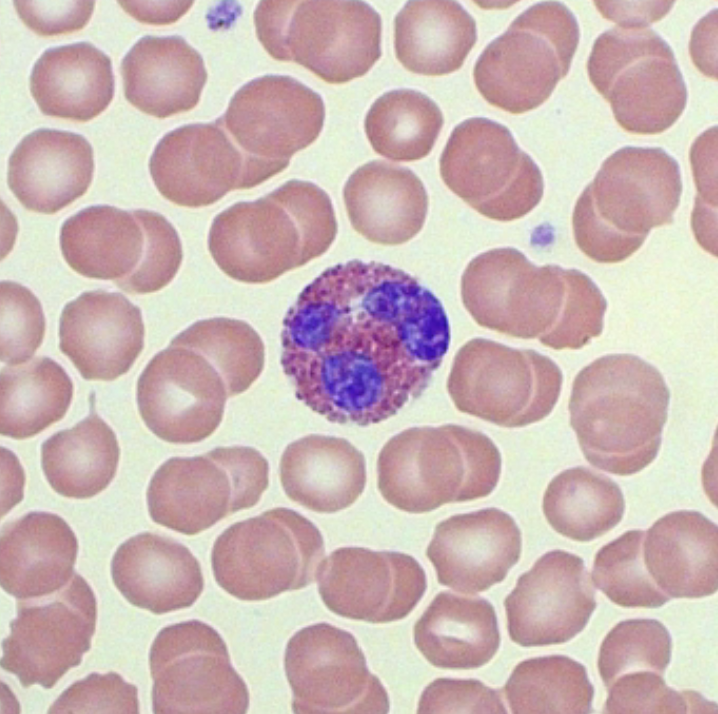
<p>What cell is this?</p>
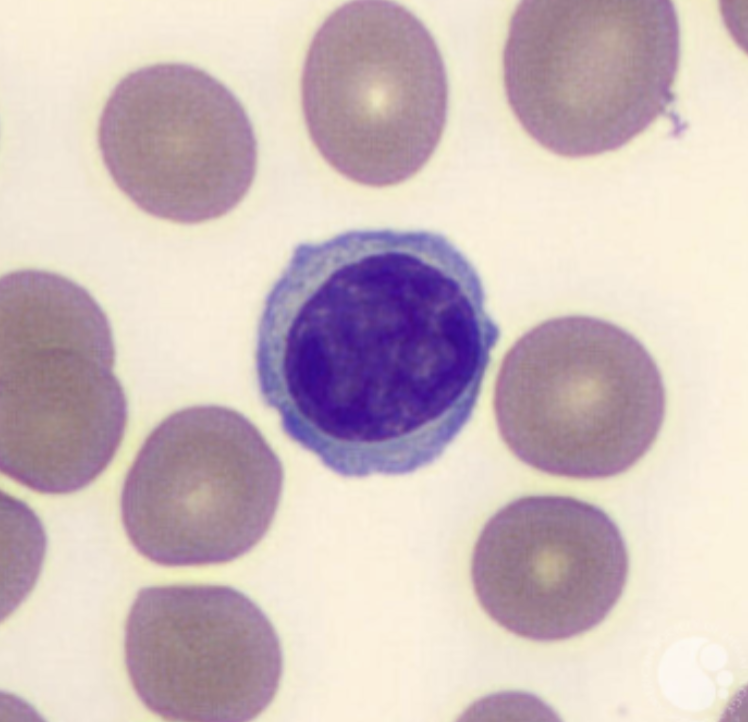
<p>What cell is this?</p>
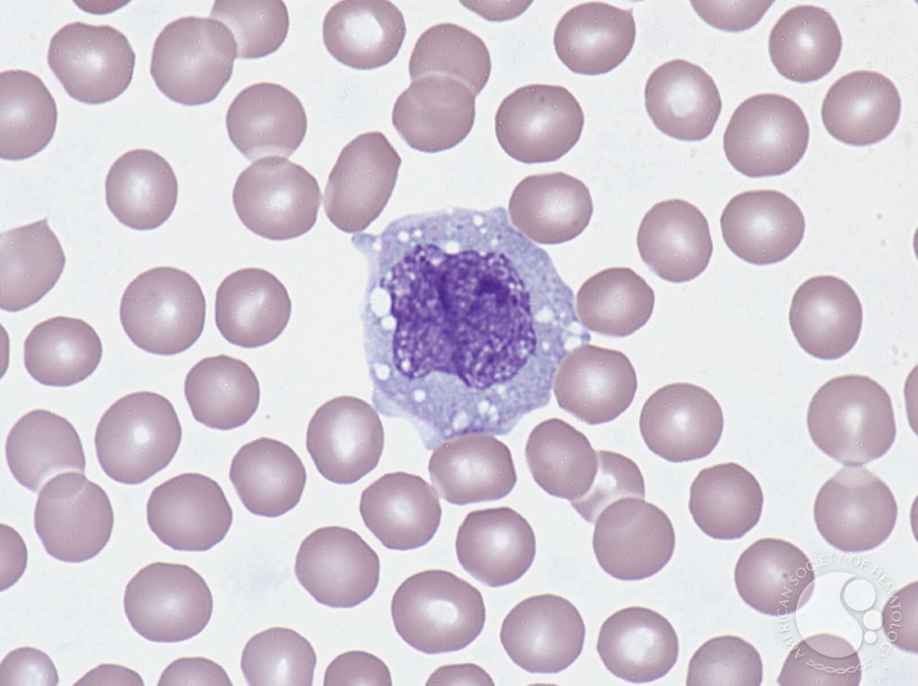
<p>What cell is this?</p>

1/6
Looks like no tags are added yet.
Name | Mastery | Learn | Test | Matching | Spaced | Call with Kai |
|---|
No analytics yet
Send a link to your students to track their progress
What is this cell?
Neutrophil
What cell is this?
Eosinophil

What cell is this?
Basophil
What cell is this?
Lymphocyte
What cell is this?
Monocyte

What are the arrows pointing to?
Platelets

What is the center cell?
Plasma cell